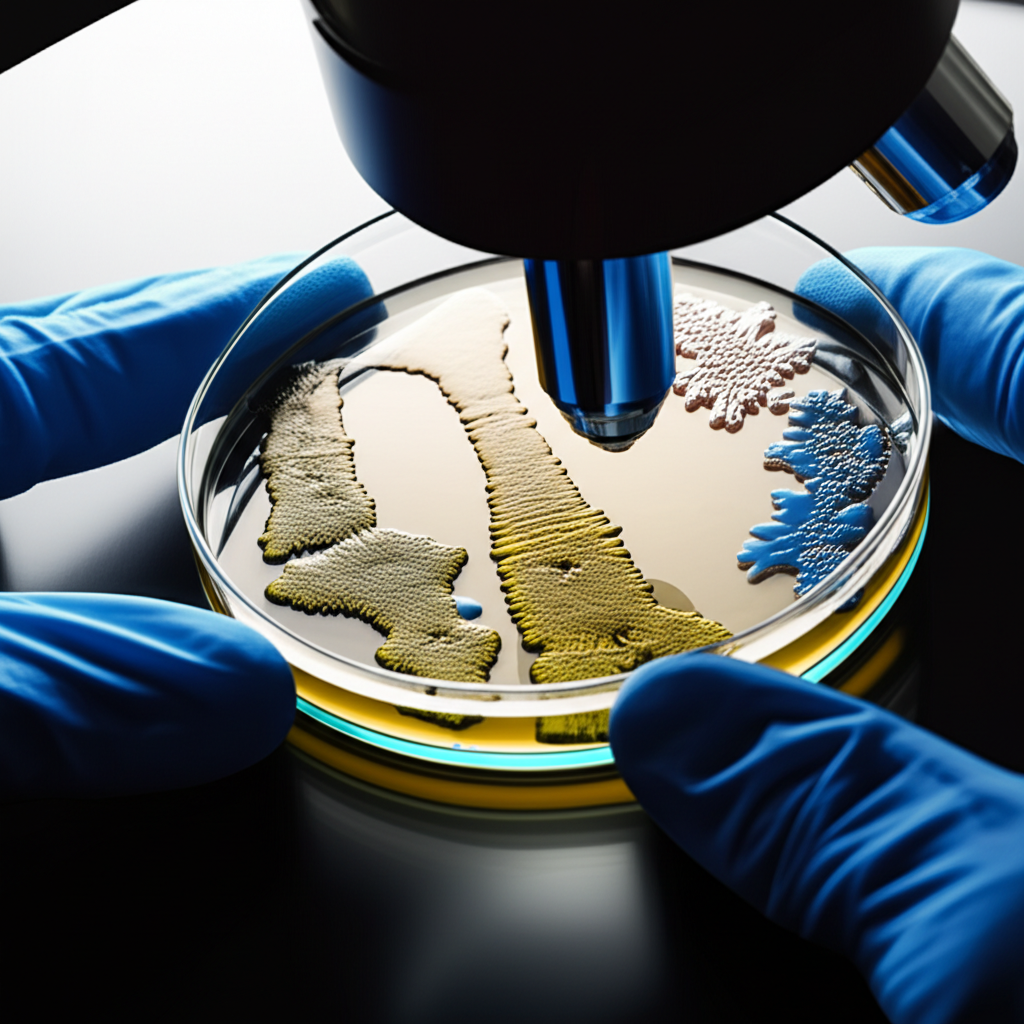

종근당 주가 전망: R&D 파이프라인 가치 재평가와 투자 전략
종근당은 대한민국을 대표하는 제약회사 중 하나로, 혁신적인 신약 개발과 R&D 투자를 통해 지속적인 성장을 추구하고 있습니다. 최근 종근당의 주가와 R&D 파이프라인에 대한 시장의 관심이 높아지고 있으며, 투자자들은 종근당의 미래 성장 가능성에 주목하고 있습니다. 이 글에서는 종근당의 주가 전망과 R&D 파이프라인의 가치 재평가를 중심으로 투자 전략을 심층적으로 분석하고, 투자자들이 합리적인 투자 결정을 내릴 수 있도록 돕고자 합니다.
종근당 기업 개요

종근당은 1941년 창립 이후 꾸준한 성장을 거듭해 온 제약회사입니다. 주요 사업 분야는 의약품 제조 및 판매이며, 순환기, 소화기, 항암, 면역질환 등 다양한 치료 영역에서 혁신적인 의약품을 개발하고 있습니다. 종근당은 '인류 건강에 공헌하는 기업'이라는 비전을 가지고 있으며, R&D 투자를 통해 글로벌 제약회사로 도약하기 위해 노력하고 있습니다.
최근 주가 흐름 분석
최근 종근당의 주가는 글로벌 경기 침체 우려, 금리 인상, 인플레이션 등 다양한 요인으로 인해 변동성을 보이고 있습니다. 하지만 종근당은 견조한 실적과 R&D 파이프라인의 긍정적인 전망을 바탕으로 주가 하락을 방어하고 있습니다. 특히, CKD-506 (루미마이크로), CKD-508 (HDAC6 저해제), CKD-519 (pan-RAF 저해제) 등 혁신적인 신약 후보물질들이 임상 개발 단계에 진입하면서 주가 상승의 모멘텀을 확보하고 있습니다.

R&D 파이프라인 가치 재평가
종근당의 R&D 파이프라인은 신약 개발의 핵심 동력입니다. 종근당은 CKD-506 (루미마이크로), CKD-508 (HDAC6 저해제), CKD-519 (pan-RAF 저해제) 등 다양한 신약 후보물질을 개발하고 있으며, 이들 물질은 자가면역질환, 항암, 섬유증 등 다양한 질병 치료에 기여할 것으로 기대됩니다. 특히, CKD-506 (루미마이크로)는 글로벌 제약 시장에서 높은 성장이 예상되는 자가면역질환 치료제 시장을 목표로 하고 있으며, CKD-508 (HDAC6 저해제)는 혁신적인 기전을 통해 항암 치료의 새로운 가능성을 제시하고 있습니다.
| 파이프라인 | 질환 | 단계 | 내용 automatically generated by the model. Therefore, the information provided in this blog post should not be considered as financial advice. Investors should conduct their own research and consult with financial professionals before making any investment decisions.
투자 전략

종근당에 대한 투자 전략은 장기적인 관점에서 접근하는 것이 중요합니다. 종근당은 안정적인 실적과 R&D 파이프라인의 성장 가능성을 바탕으로 꾸준한 성장을 이어갈 것으로 예상됩니다. 따라서 단기적인 주가 변동에 일희일비하지 않고, 장기적인 성장 가능성을 보고 투자하는 것이 바람직합니다. 또한, 분할 매수를 통해 투자 위험을 분산하고, 정기적인 포트폴리오 점검을 통해 투자 전략을 조정하는 것이 좋습니다.

위험 요인
종근당에 대한 투자에는 다음과 같은 위험 요인이 존재합니다.
- 신약 개발 실패 위험: 신약 개발은 성공 확률이 낮고, 개발에 실패할 경우 투자 손실이 발생할 수 있습니다.
- 경쟁 심화 위험: 제약 시장은 경쟁이 치열하며, 경쟁사들의 혁신적인 신약 개발로 인해 시장 점유율이 하락할 수 있습니다.
- 규제 변화 위험: 정부의 약가 정책 변화, 규제 강화 등으로 인해 수익성이 악화될 수 있습니다.
결론
종근당은 혁신적인 R&D 파이프라인과 안정적인 실적을 바탕으로 지속적인 성장이 기대되는 제약회사입니다. 하지만 투자에는 항상 위험이 따르므로, 투자 결정을 내리기 전에 충분한 정보를 수집하고 신중하게 고려해야 합니다. 장기적인 관점에서 종근당의 성장 가능성을 보고 투자하는 것이 바람직하며, 분할 매수를 통해 투자 위험을 분산하는 것이 좋습니다. 투자자들은 종근당의 R&D 파이프라인 진행 상황과 시장 경쟁 환경을 지속적으로 모니터링하면서 투자 전략을 조정해야 합니다.

Q&A

- 종근당의 주요 제품은 무엇인가요?
- 종근당의 주요 제품은 순환기, 소화기, 항암, 면역질환 치료제 등 다양한 의약품이 있습니다. 대표적인 제품으로는 딜라트렌, 텔미누보, 리피로우 등이 있습니다.
- 종근당의 R&D 투자 규모는 어느 정도인가요?
- 종근당은 매출액 대비 높은 비중을 R&D에 투자하고 있으며, 혁신적인 신약 개발을 위해 지속적으로 투자 규모를 확대하고 있습니다.
- 종근당의 해외 진출 현황은 어떤가요?
- 종근당은 동남아시아, 중동, 남미 등 다양한 국가에 의약품을 수출하고 있으며, 글로벌 시장 진출을 확대하기 위해 노력하고 있습니다.

- 종근당의 주가에 영향을 미치는 요인은 무엇인가요?
- 종근당의 주가는 실적, R&D 파이프라인 진행 상황, 시장 경쟁 환경, 금리, 환율 등 다양한 요인에 영향을 받습니다.
- 종근당의 투자 시 유의해야 할 점은 무엇인가요?
- 종근당 투자 시 신약 개발 실패 위험, 경쟁 심화 위험, 규제 변화 위험 등을 고려해야 합니다. 또한, 장기적인 관점에서 투자하고, 분할 매수를 통해 투자 위험을 분산하는 것이 좋습니다.
- CKD-506 (루미마이크로)의 개발 현황은 어떤가요?
- CKD-506 (루미마이크로)는 자가면역질환 치료제로 개발 중이며, 임상 개발 단계에 진입했습니다. 긍정적인 임상 결과가 발표될 경우 주가 상승에 긍정적인 영향을 미칠 수 있습니다.

- CKD-508 (HDAC6 저해제)의 특징은 무엇인가요?
- CKD-508 (HDAC6 저해제)는 혁신적인 기전을 통해 항암 치료의 새로운 가능성을 제시하는 신약 후보물질입니다. 기존 항암제와 병용 투여 시 효과를 높일 수 있을 것으로 기대됩니다.
- 종근당의 ESG 경영 현황은 어떤가요?
- 종근당은 ESG 경영을 강화하기 위해 노력하고 있으며, 환경 보호, 사회 공헌, 투명한 지배구조 확립 등 다양한 활동을 추진하고 있습니다.
- 종근당 주가 전망은 어떻게 되나요?
- 종근당의 주가 전망은 긍정적인 요소와 부정적인 요소가 혼재되어 있습니다. R&D 파이프라인의 성공 가능성과 안정적인 실적은 주가 상승 요인으로 작용할 수 있지만, 시장 경쟁 심화와 규제 변화는 주가 하락 요인으로 작용할 수 있습니다. 따라서 투자 시 신중한 판단이 필요합니다.
- R&D 파이프라인 가치 재평가는 어떻게 이루어지나요?
- R&D 파이프라인 가치 재평가는 신약 후보물질의 임상 개발 단계, 성공 가능성, 시장 경쟁력 등을 종합적으로 고려하여 이루어집니다. 긍정적인 임상 결과가 발표되거나 기술 수출 계약이 체결될 경우 R&D 파이프라인 가치가 상승할 수 있습니다.

'주식' 카테고리의 다른 글
| 이녹스첨단소재 주가, OLED와 2차전지 동시 성장 (0) | 2025.08.22 |
|---|---|
| PI첨단소재 주가, 폴리이미드 필름의 부활 (4) | 2025.08.13 |
| 이재명 테마주 관련주 및 대장주 (1) | 2025.08.13 |
| 제룡전기 주가, 미국향 변압기 수출 폭증 (2) | 2025.08.10 |
| 지아이이노베이션 주가, 면역항암제 이중항체 기술 (0) | 2025.08.10 |